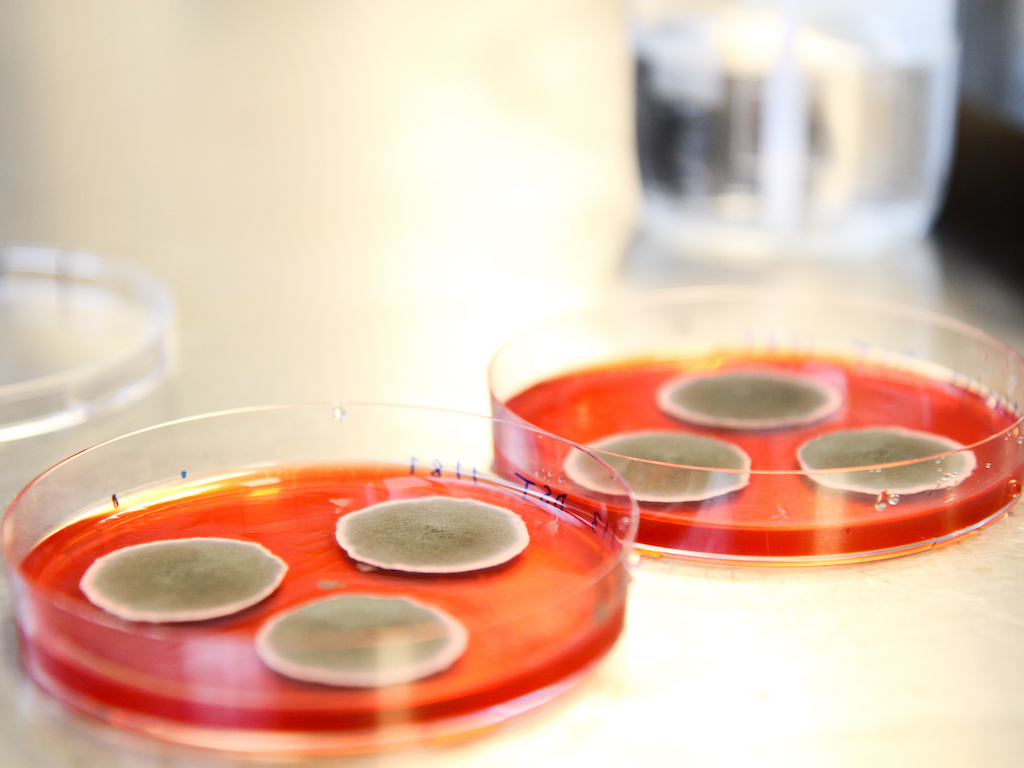

Chromologics Closes €6M Seed Round to Develop Vegan Food Colourants
Danish startup Chromologics has closed its seed round with €6 million (US$7.14 million), after receiving an additional €4 million (US$4.76 million) from a number of investors. The company uses precision fermentation to develop animal-free natural food colourants, and will use the funding to continue expanding its fungal biotech platform of bio-based colourants.
Chromologics has raised additional funding from a number of venture capitalists, including Zürich-based Blue Horizon Ventures, Nordics-focused life sciences investor Novo Seeds, and early-stage food tech VC Nordic Food Tech. Angel investor Giampaolo Cagnin also joined the round, bringing the total of its seed round up to €6 million (US$7.14 million).
The startup previously raised seed funding from Vækstfonden, the investment arm of the Danish government. Prior to the round, Chromologics was financed by grants from the Novo Nordisk Foundation and the Innovation Foundation Denmark.

Chromologics’ precision fermentation colourants
Born out of research from the Technical University of Denmark (DTU) in 2017, the startup uses precision fermentation to develop its bio-based portfolio of natural colorants. The aim is to disrupt the US$2 billion food colourant market with its animal-free food-grade colourants that can function just like their traditional counterparts.
Current alternatives to animal-based food colourants are made from plant-based raw materials, which tends to be expensive. Chromologics has managed to leverage precision fermentation to use non-GMO fungal strains to create an alternative to carmine, a red pigment that is at present made from crushed beetles and cochineal insects.
Called ChromoRed, their flagship red food colourant can be produced cheaply and on a large-scale, and is compatible with kosher, halal, and vegan diets. It is also temperature stable and bears the optimal pH for a wide range of applications in food products.
Funding to accelerate regulatory approval and R&D
Chromologics says the investment will help accelerate its process of gaining regulatory approval of ChromoRed before launching it onto the market. Currently, the company is seeking new partnerships in the food industry.
In terms of its clientele, the startup is actively looking to collaborate with plant-based meat producers to use its ChromoRed food dye, which can elevate the appearance and resemblance of analogues to its real animal-based counterparts.

Our ambition is to grow Chromologics into the market leader of fermented natural colour solutions.
Gerit Tolborg, Co-Founder & CEO, Chromologics
Chromologics also plans to use the funding to expand its portfolio of bio-based natural colourants developed using precision fermentation to “address other market segments”.
“Our journey of successfully translating academic science into a commercial product is just beginning,” commented Gerit Tolborg, CEO and co-founder of the startup. “Our ambition is to grow Chromologics into the market leader of fermented natural colour solutions.”
Founding the startup with fellow DTU academic Anders Ødum, Tolborg added that as one of the few female CEOs in the tech startup world, she hopes to serve as an “inspiration for other female scientists to follow suit.”

Precision fermentation solutions to ‘radically transform global colour industry’
Speaking about the decision to back Chromologics, Thomas Grotkjær, principal at Novo Seeds, said that the extended seed funding round with a number of European backers was a “clear sign of the momentum” surrounding precision fermentation technologies.
“I believe that Chromologics has the potential to drive a significant change in how we think about natural colours,” said Grotkjær.
“Their technology has the potential to radically transform the global colour industry as it opens the door for nature-based, safe, and reliable colours to the food and beverage industry that can be produced with far fewer resources,” added Regina Hecker, partner at Blue Horizon.
It opens the door for nature-based, safe, and reliable colours to the food and beverage industry that can be produced with far fewer resources.
Regina Hecker, Partner, Blue Horizon
Chromologics isn’t the only startup using novel technologies to disrupt the food colourant market. Israeli firm Phytolon, for instance, has developed a proprietary fermentation-based method to produce natural animal-free food colourants in baker’s yeast. The startup recently secured US$4.1 million in funding to fuel its go-to-market plans.
All images courtesy of Chromologics.